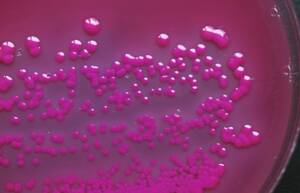

Bestehen nach drei Tagen einer unspezifischen Behandlung die Beschwerden fort, ist meist ein Antibiotikum nötig. Weitere Anzeichen, bei denen zu einem Arztbesuch geraten werden sollte, sind Schmerzen in der Nierengegend, allgemeines Krankheitsgefühl und Fieber, verfärbter oder blutiger Urin, extreme Schmerzen und Krämpfe beim Wasserlassen. Auch bei Kindern, Männern, Schwangeren, Diabetikern, Immunsupprimierten oder Patienten mit Niereninsuffizienz ist von einer komplizierten Zystitis auszugehen.
Doch auch diese Patienten sind über Hinweise dankbar, was sie zusätzlich zu einer vom Arzt verordneten Antibiotikatherapie tun können. Neben Wärme (feuchte Wickel oder Wärmflasche), Schonung und Spasmolytika wie Butylscopolamin (wie Buscopan®) ist es die Durchspülungstherapie, die nach ein paar Tagen Linderung bringt. Geeignet sind fertige Teezubereitungen (wie Harntee 400 TAD® N, Hevert® Blasen-Nieren-Tee N) und andere Darreichungsformen (wie Cystinol long®, Canephron®, Urorenal®, Cysto Hevert®) mit Extrakten aus verschiedenen Arzneipflanzen. Nicht zu vergessen: Parallel zu Kapseln, Dragees oder Tropfen ist reichlich Flüssigkeit aufzunehmen.
Auch lose Teedrogen haben sich bei Harnwegsinfekten bewährt, wie Birkenblätter, Orthosiphonblätter, Hauhechelwurzel, Brennnesselkraut, Schachtelhalmkraut oder Goldrutenkraut. Letzteres soll über den aquaretischen Effekt hinaus noch eine entkrampfende und antiphlogistische Wirkkomponente haben. Beratungstipp: Auch wenn die Antibiotika-Einnahme beendet ist und die Beschwerden abgeklungen sind, sollten Blase und Harnleiter noch eine Weile gut durchspült werden. Umso gründlicher können die pflanzlichen Aquaretika ihre Arbeit verrichten und eventuell verbliebenen pathogenen Keimen ein Anheften schwer machen. Valide In-vivo-Daten zur Wirksamkeit der Aquaretika existieren freilich nicht, auch wenn die Kommission E des ehemaligen Bundesgesundheitsamtes die genannten Drogen positiv bewertet hat. Kritiker reduzieren deren Effekt auch auf die zugeführte Flüssigkeitsmenge.
Von den gebräuchlichen Heilpflanzen stechen nur drei Vertreter mit deutlich antimikrobiellem Potenzial heraus: die Blätter der Bärentraube (wie Cystinol akut®, Arctuvan®) und die Fixkombination aus Meerrettichwurzel und Kapuzinerkressenkraut. Die In-vitro-Daten für beide Harnwegsdesinfizienzien überzeugen, und zumindest die Senföl-Fixkombination hat auch respektable In-vivo-Studien vorzuweisen.